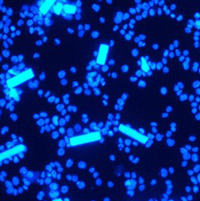

Materials for biomedical application
Materials for biomedical application group is composed of active research staff and diverse research projects since materials are forming strong supportive and standalone role in multiple research directions, especially in regenerative medicine, tissue engineering, drug testing and development, and fabrication of new medical devices.
Our research themes

Biomaterials for cardiac tissue engineering
The theme looks at developing the potential of biomaterials for improving models of cardiovascular disease conditions and to examine their translational applications.
Read more
Biomaterials for drug delivery
The recent advances in the synthesis and characterisations of novel biomaterials have significantly influenced the traditional approaches in the treatment of diseases and replaced them with the more efficacious therapies.
Read more
Biomaterials for musculoskeletal engineering
The musculoskeletal system is a complex interacting network of multiple tissues with highly differing mechanical characteristics, junctions and secretory bodies. Damage to this system occurs frequently as a result of aging, disease aetiology, inherent properties of the cells, substantial loss of tissue (as in the case of limb loss or severe burns) or acute injury.
Read more
Immunomodulatory biomaterials
Biomedical implants and tissue engineering methods are enabling technologies to improve or even restore the function of diseased organs.
Read more
Smart fabrication techniques
Here in Keele University, we have developed a facile but effective collector with parallel electrodes for low density aligned nanofiber collection in electrospinning technique.
Read more
Smart magnetic biomaterials
In the last decade, smart magnetic biomaterials have found an increasing number of applications in biomedicine.
Read moreResearchers

Dr Chris Adams
Lecturer in Neuroscience
- Huxley Building : 166
- +44 (0)1782 733943
- c.adams@keele.ac.uk

Dr David Cabrera
Lecturer in Bioengineering
- Guy Hilton Research Centre
- +44 (0)1782 671654
- d.c.cabrera@keele.ac.uk

Professor Divya Maitreyi Chari
Professor of Neural Tissue Engineering
- Huxley Building : 225
- +44 (0)1782 733314
- d.chari@keele.ac.uk

Ruoli Chen
Senior Lecturer in Clinical Pharmacy and Pharmacology
- Hornbeam 2.28
- +44 (0)1782 733849
- r.chen@keele.ac.uk

Dr Pooya Davoodi
Lecturer (Assistant Professor) in Pharmaceutics
- Hornbeam 1.12
- p.davoodi@keele.ac.uk

Dr Vinoj George
Lecturer in Stem Cell Biology & Regenerative Medicine
- Guy Hilton Research Centre
- +44 (0)1782 674383
- v.george@keele.ac.uk

Dr Alan Harper
Senior lecturer in Physiology
- Teaching - David Weatherall Research - Guy Hilton Laboratories
- +44 (0)1782 734654
- a.g.s.harper@keele.ac.uk

Dr Stuart Jenkins
Lecturer in Neurobiology
- Huxley 2.25
- +44 (0)1782 733874
- s.i.jenkins@keele.ac.uk

Dr Patricia Ragazzon
Senior Lecturer in Pharmaceutical Sciences
- Hornbeam 2.26
- +44 (0)1782 734767
- p.ragazzon@keele.ac.uk

Professor Neil Telling
School Research Director, Professor of Biomedical NanoPhysics
- Guy Hilton Research Centre, Room 13; Hornbeam Building 1.14
- + 44 (0) 1782 674968
- n.d.telling@keele.ac.uk

Professor Ying Yang
Professor in Biomaterials and Tissue Engineering
- Guy Hilton Research Centre
- +44 (0)1782 674386
- y.yang@keele.ac.uk